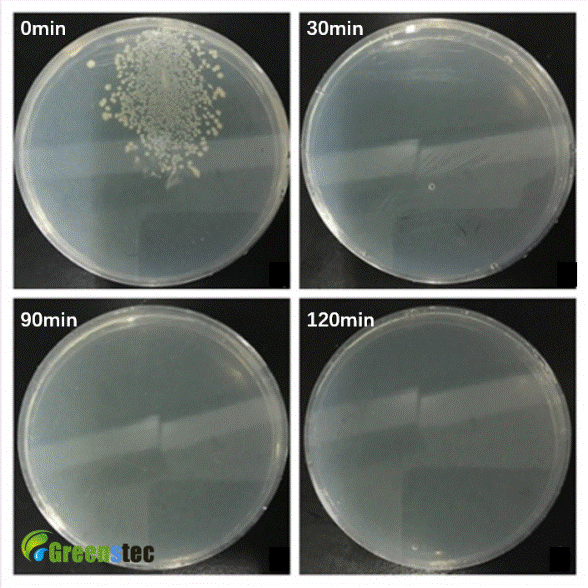

专注工业废液 · 污水处理 · 污染空气治理
专注工业废液 · 污水处理 · 污染空气治理

021-68028885
 专注工业废液 · 污水处理 · 污染空气治理
专注工业废液 · 污水处理 · 污染空气治理

021-68028885

联系人:赵经理
电话:021-68028885
手机:17765161285
邮箱:sales@greenstec.com
地址:上海市浦东新区海基六路218弄15号
金属切削液是一种在机械加工中使用的工业润滑介质,据统计全球切削液原液的使用量从2005年的3800万吨上升至2015年的4256万吨。切削液若维护管理不当,会因杂油、杂质、微生物等污染变成废切削液,在使用过程中腐败变质,各因素“沆瀣一气”会降低切削液pH值、弱化切削液中油水平衡、产生恶臭气体。
废切削液对机床、车间、工人的身体健康,都有着较大的危害。废切削液中的金属切屑、屑泥或微生物膜会堵塞泵、管道等机床供液系统,影响机床正常使用;废切削液pH值呈酸性,对刀具、机床等造成严重腐蚀,一旦产生小孔腐蚀则会导致管道穿孔造成供液系统泄露,导轨生锈、工件报废;废切削液中的微生物会对金属造成严重腐蚀,据研究报道WC硬质合金刀具在含硫酸盐还原菌的切削废液中腐蚀速率大大高于其在新液中的腐蚀速率;废切削液中含有某些病原体,工人长期接触废切削液会罹患过敏性肺炎、哮喘甚至肺癌等呼吸道疾病,造成较大的健康威胁。
目前废切削液均交由环保公司处理,而环保公司多采用传统处理方法,如膜过滤、气浮、厌氧/好氧细菌氧化等,均需添加药剂易造成二次污染,部分反应条件苛刻易造成较大能源消耗。国内切削废液处理成本昂贵大约为3000~8000元,同时环保公司的处理能力有限,采取配额处理方式,造成企业切削废液排不出而新液又无法及时加入的“窘境”,较大影响了企业的产能和环境。
据上海绿晟环保科技有限公司研究人员发现,大多数企业认为的切削废液其实大部分成分并未失效,而上海绿晟环保科技有限公司自主研发的光电解聚合氧化技术、纳米空泡技术、主动式分子凝聚技术,能有效使切削废液再生回用,并基于以上技术开发了不同处理侧着重的切削废液净化再生设备。
GSH-Q60X系列切削液净化再生处理设备是一台针对集中供液式的切削废液净化再生回用处理设备。集先进环境净化纳米材料和复合氧化技术为一身的切削废液净化再生回用新型产品,采用国际先进的纳米空泡及自由基氧化技术,具有对水性切削液进行有效再生、除油、杀菌、除臭、提升pH值和润滑度等多重功效。

GSH-Q60X系列切削液净化再生设备
该设备在研制成功后在上海天合石油工程股份有限公司进行了测试,对其某机床液槽中200升已劣化切削废液进行了处理,结果显示切削废液中的微生物在2小时内全部被杀灭,处理后的切削液完全可以返回机床再次使用。

GSH-Q601切削液净化再生设备在天合石油现场处理照片
设备杀菌效果图

液槽处理效果图
